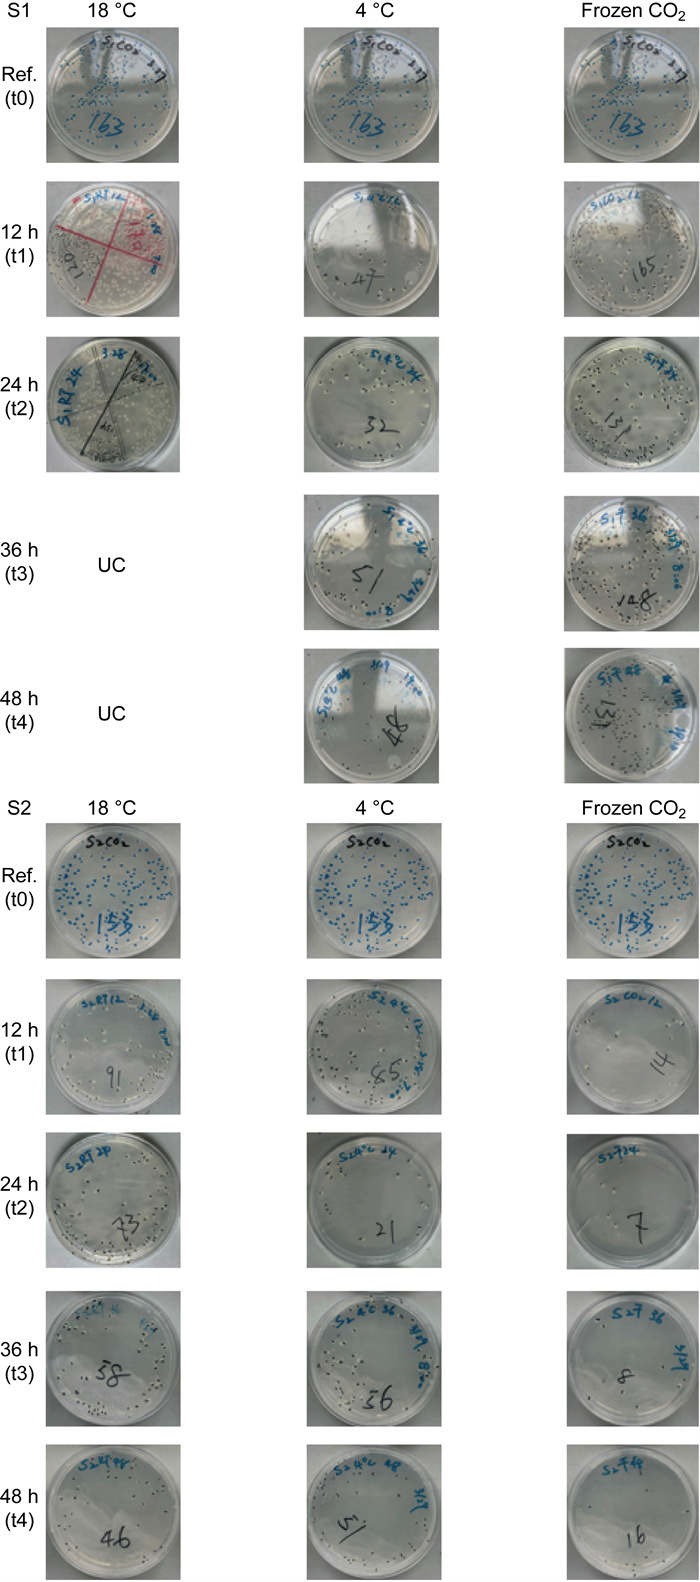

2. 上海市疾病预防控制中心病原生物检定所,上海 200336;
3. 上海市疾病预防控制中心,上海 200336
2. Pathogen Control Institute, Shanghai Municipal Center for Disease Control and Prevention, Shanghai 200336, China;
3. Shanghai Municipal Center for Disease Control and Prevention, Shanghai 200336, China
公共卫生样本是公共卫生管理体系的重要基础设施和战略发展资源,其合理利用不但可以掌握人口的健康状况、评价疾病的防治效果、提高疾病的预防和控制水平,实现疾病预防控制重心前移,为政府决策提供依据,还可以揭示疾病的起因、疾病发生的自然史,为探索致病机理提供更广阔的研究思路[1]。疾病预防控制机构承担区域内公共卫生样本的资源收集、样本库规划、建设和管理功能等工作,依托样本库产出的科研结果,其稳定性和可重复性在很大程度上依赖于样本及其关联信息的质量[2],样本库工作目标应尽量反映样品真实的“原始”状态,通过新理论研究和新技术研发尽可能地识别、发现、评估可能造成样本质量变化的因素,并减少其对样本质量的影响。
公共卫生样本监测项目涉及不同种类样本的微生物学检验。尽管微生物的分子诊断技术快捷、准确、灵敏度高,包括:核酸扩增[荧光定量聚合酶链反应(polymerase chain reaction,PCR)、巢式PCR、多重PCR、逆转录PCR、数字PCR、等温扩增]、核酸杂交(基因芯片)、基因测序(扩增子测序、宏基因组测序、全基因组测序)等[3],但仍无法替代传统微生物鉴定“金标准”,即须从样本中分离培养出病原微生物,包括细菌、病毒、真菌等具有活性的生命体。因此,如何保证样本采集、转运、暂存、保藏和再利用工作流程中样本的微生物活性,是公共卫生样本质量控制的关键点。
公共卫生生物样本库的样本收集与利用具有自身独特性[4]。与临床生物样本库相比,公共卫生生物样本具有采集环境复杂、样本转运暂存时间长、样本前处理涉及实验室多、收集样本类型众多、人群队列长期随访的样本保藏时间长[5]以及短期内不会出库利用等特征。因此,全流程质量控制对于公共卫生样本库各类人体生物样本、动物样本和环境样本采集、运输、暂存和保藏的标准化具有一定的挑战性。
近年来,健康人群中肠道微生态与健康和疾病的关系是研究的热点[6-7],胃肠道菌群可被视为一个微生物器官,在体内发挥作用,影响代谢、营养和免疫系统[8]。粪菌移植(fecal microbiota transplantation, FMT)可将从健康人群粪便中分离得到的功能菌群移植到患者胃肠道,通过重建患者肠道菌群而实现对疾病的治疗[9-10]。在制备用于FMT的粪便样本时,将粪便中包含的完整、稳定的粪菌群落从健康供者转移到患者,解决疾病症状须依赖样本库保藏质量的全面提升。本研究抽象出2个样本库工作场景,分别是:转运/暂存场景、冷冻保藏再利用场景,初步评价血清和环境水体2种类型标本在不同温度、时间和冻融次数条件下[11],尤其在液氮温区环境下样本中大肠埃希菌活性的变化,为今后样本中微生物活性功能研究,如:肠道微生态研究、粪菌治疗、环境微生态对健康的影响等,提供样本采集、转运和保藏管理要求的科学数据。
1 材料与方法 1.1 材料 1.1.1 仪器与试剂4 ℃ BC/BD-203H型冰箱(中国山东海尔公司);-20 ℃卧式冰柜(中国海尔公司);-80 ℃冰箱(中国Meling公司);液氮罐(美国Thermolyne公司);18 ℃培养箱(德国Binder公司);37℃ GRP-9160型隔水恒温培养箱(中国上海森信公司);麦氏比浊仪(美国BioMerieux Densimat公司);VORTEX-GENIE2型涡旋振荡器(美国Scientific Industries公司);DK-600B型水浴箱(中国上海森信公司);L型涂布棒(美国Biologix公司);营养琼脂培养基(中国上海科玛嘉公司);0.85 g/mL氯化钠溶液(美国BioMerieux公司)。
1.1.2 加标菌液与模拟样本加标菌液浓度确定:挑取革兰氏阴性菌大肠埃希菌(ATCC25922)单个克隆,用0.85 g/mL浓度的NaCl溶液将菌悬液调至0.5麦氏浊度单位(McFarland,MCF)后依次10倍稀释至10-5,再取50 μL立即涂布于营养琼脂平板,培养24 h后菌落计数,确定加标菌液的浓度。模拟样本制备:按照大肠埃希菌加标菌悬液板不同稀释度平板计数结果(见表 1),将加标菌液与兔血清样本和饮用水样本分别以1∶9的比例混合,并迅速于涡旋振荡器反复振荡混匀3次,分装至2 mL冻存管进行后续实验。
| 10-1 | 10-2 | 10-3 | 10-4 | 10-5 | |
| Number of colonies | UC | UC | UC | 244.67±8.89 | 114.56±7.52 |
| UC: Uncountable. | |||||
模拟公共卫生样本库在样本实际采集后转运/暂存可能遇到的工作场景:在常温、冷藏和干冰条件下分别当天转运/暂存、隔天转运/暂存、2天转运/暂存、3天转运/暂存。将2种模拟样本按照表 2的温度放置规定时间取出,取50 μL立即涂布于营养琼脂平板,培养24 h后菌落计数。每批实验均设置无菌兔血清样本和饮用水样本作为阴性对照。
| Temperature | 12 h(t1) | 24 h(t2) | 36 h(t3) | 48 h(t4) |
| 18 ℃ | 常温暂存当天运输 | 常温暂存隔天运输 | 常温暂存2天运输 | 常温暂存3天运输 |
| 4 ℃ | 冷藏暂存当天运输 | 冷藏暂存隔天运输 | 冷藏暂存2天运输 | 冷藏暂存3天运输 |
| Frozen CO2 | 干冰暂存当天运输 | 干冰暂存隔天运输 | 干冰暂存2天运输 | 干冰暂存3天运输 |
模拟不同冷冻温度保藏反复冻融后再使用的工作场景,将血清和饮用水样本与大肠埃希菌加标液预混后分别置于-20 ℃、-80 ℃和液氮条件下短期保藏一周,反复冻融6次,每次37 ℃迅速融化至无固形物,立即涂布于营养琼脂平板,培养24 h后菌落计数。每批实验均设置无菌兔血清样本和饮用水样本作为阴性对照。
1.2.3 研究不同温度、冻融次数下不同浓度血清对细菌活性的保护作用用0.85 g/mL的NaCl溶液与兔血清按照1∶9,1∶1,9∶1的比例混合,将兔血清梯度稀释为原浓度的90%、50%、10%;再取0.9 mL 0.85 g/mL NaCl溶液,分别加入以上3种浓度的稀释兔血清样本,稀释至原溶液浓度的10-3,取细菌悬液0.1 mL涡旋充分混匀,立即于-20 ℃、-80 ℃冻存,一周后分别冻融1、3、5次,取50 μL均匀涂抹于营养琼脂平板上,37 ℃培养24 h后计数。
1.2.4 统计学处理运用Excel 2021建立数据库,使用SPSS 19.0进行统计学分析。通过配对t检验法比较各时点检测值与基准值的差异,P < 0.05时认为检测值与基准值的差异具有统计学意义。
2 结果 2.1 加标菌液浓度确定挑取革兰氏阴性菌大肠埃希菌(ATCC25922)单个克隆,用0.85 g/mL NaCl溶液将菌悬液调至0.5 MCF后,依次10倍稀释至10-5,取50 μL立即涂布于营养琼脂平板,培养24 h后菌落计数,稀释到10-4和10-5时平板菌落计数均小于300个(见表 1)。一方面为了方便后续实验的细菌菌落平板计数;另一方面,根据前期文献和实验的经验,低温保存尤其是反复冻融会降低细菌活性,因此,选择加标大肠埃希菌菌悬液的最终浓度为0.5 MCF后再依次10倍稀释至10-3。
2.2 转运/暂存场景中不同温度、时间对菌活性的影响实验模拟了感染性血清和饮用水样本采集后分别置于18 ℃、4 ℃和干冰条件下分别暂存12 h、24 h、36 h和48 h后样本中大肠埃希菌菌落数量的变化(见图 1)。
|
| S1: Rabbit serum, S2: Drinking water, Ref: Reference group, UC: Uncountable 图 1 不同运输温度、运输时间各样本中大肠埃希菌平板计数实验 Fig. 1 Experiments of Escherichia coli plate counts in samples with different transit temperatures and transit times |
结果显示(见表 3),血清模拟样本在18 ℃条件下,随着保存时间的延长,样本中大肠埃希菌数量呈指数级增加;4 ℃保存条件下,大肠埃希菌数量随着保存时间的延长呈减少趋势,12 h(P=0.000)、24 h(P=0.000)、36 h(P=0.000)、48 h(P=0.000)的菌落计数与基准值(t0)的差异均具有统计学意义。干冰保存条件下,菌落数在12 h(P=0.381)和24 h(P=0.087)与基准值(t0)无显著差异,36 h(P=0.000)和48 h(P= 0.000)菌落数减少且与基准值(t0)有显著差异。
| Group | Ref t0 | 12 h t1(t, P) | 24 h t2(t, P) | 36 h t3(t, P) | 48 h t4(t, P) |
| 18 ℃ RS | 95.67±16.294 | 502.00±164.722 (-7.650, 0.000) | 1 048.67±62.139 (-42.823, 0.000) | UC | UC |
| 4 ℃ RS | 95.67±16.294 | 56.33±18.908 (26.722, 0.000) | 48.00±10.977 (16.853, 0.000) | 44.00±16.109 (15.882, 0.000) | 48.33±7.649 (15.202,0.000) |
| Frozen CO2RS | 163.00±18.466 | 160.00±11.737 (0.927, 0.381) | 151.33±31.528 (1.947, 0.087) | 140.00±26.80 (6.944, 0.000) | 134.67±13.829 (12.465, 0.000) |
| 18 ℃ DW | 83.11±4.372 | 93.33±12.093 (-3.342, 0.010) | 63.67±22.011 (2.986, 0.017) | 58.67±4.062 (44.000, 0.000) | 40.00±12.217 (12.147,0.000) |
| 4 ℃ DW | 83.11±4.372 | 92.67±19.729 (-1.729, 0.122) | 30.00±18.255 (10.795, 0.000) | 51.67±7.416 (14.257, 0.000) | 45.67±10.087 (12.499, 0.000) |
| Frozen CO2DW | 144.33±22.793 | 13.33±3.708 (20.261, 0.000) | 7.67±2.000 (19.179, 0.000) | 8.33±4.093 (21.175, 0.000) | 16.33±4.093 (19.850.0.000) |
| Ref: Reference group, RS: Rabbit serum, DW: Drinking water, UC: Uncountable. | |||||
在18 ℃保存条件下,饮用水模拟样本中大肠埃希菌菌落数随着保存时间的延长呈减少趋势,12 h(P=0.010)、24 h(P=0.001 7)、36 h(P=0.000)、48 h(P=0.000)的菌落计数与基准值(t0)的差异均具有统计学意义。4 ℃保存条件下,12 h(P=0.122)与基准值(t0)菌落计数差异不显著,其余时间点均与基准值(t0)有显著差异。饮用水模拟样本在干冰保存条件下保存12 h后,菌落数量迅速减少10倍以上,之后24 h、36 h、48 h时间点的菌落数稳定在相似水平。
通过对感染性血清模拟样本及感染性饮用水模拟样本中的大肠埃希菌进行菌落计数,以菌落数量表示其活性,并对不同运输温度、运输时间下的相关性进行分析(见图 2),在4 ℃和干冰冷藏的运输条件下,感染性血清模拟样本中的大肠埃希菌菌落数量均随着时间呈逐步下降趋势。4 ℃条件下,大肠埃希菌菌落数从t1(12 h)开始下降,至t4(48 h)出现小幅度波动;干冰条件下的大肠埃希菌菌落数量相对4 ℃下降幅度较小。在18 ℃模拟室温运输条件下,样本中的大肠埃希菌菌落数量在t1(12 h)后开始增加,t2(24 h)后呈指数级增加。

|
| A: Rabbit serum; B: Drinking water. 图 2 不同运输温度、运输时间与样本中大肠埃希菌活性的相关性分析 Fig. 2 Correlation analysis between different transit temperatures, transit times and Escherichia coli activity in samples |
感染性饮用水模拟样本在18 ℃、4 ℃冷藏条件下,样本中的大肠埃希菌菌落数量变化趋势相似,样本中大肠埃希菌菌落数量在t1(12 h)略有增加后呈现逐步下降的趋势,而18 ℃室温条件下,在t2(24 h)、t3(36 h)和t4(48 h)菌落数下降变缓。值得注意的是,干冰冷藏运输条件下,菌落数在t1(12 h)即下降至极低水平。
2.3 冷冻保藏再利用场景中不同温度、冻融次数对菌活性的影响实验模拟感染性血清和饮用水样本分别置于-20 ℃、-80 ℃和液氮条件下短期保藏1周后反复冻融6次,观察每次冻融后样本中大肠埃希菌活性的变化情况(见图 3)。

|
| S1:Rabbit serum, S2:Drinking water, F0: Reference group. 图 3 不同保藏温度、冻融次数下各样本中大肠埃希菌平板计数实验 Fig. 3 Experiments of Escherichia coli plate counts in samples with different holding temperatures and different freeze-thaw cycle times |
从冻融次数对结果影响方面来看(见表 4),第1次冻融后,血清模拟样本在-20 ℃、-80 ℃和液氮条件下,菌落数比基准值F0略有增加,但差异均不显著(-20 ℃下P=0.195,-80 ℃下P=0.310,P>0.05);第2次冻融后,血清模拟样本在-80 ℃和液氮条件下,菌落数与第1次冻融结果相似,与基准值相比略有增加但差异均不显著(P>0.05);第3次冻融后,血清模拟样本仅在液氮条件下,菌落数较于基准值F0减少,但差异无统计学意义(P>0.05);第4次冻融后,血清模拟样本在-20 ℃、-80 ℃和液氮条件下,菌落数均与基准值F0有显著性差异(P < 0.05)。而饮用水模拟样本在-20 ℃、-80 ℃和液氮条件下,从第1次冻融开始均与基准值F0存在显著性差异(P < 0.05),且菌落数量随着保藏温度的降低而增加。
| Group | Ref F0 | F1(t, P) | F2(t, P) | F3(t, P) | F4(t, P) | F5(t, P) | F6(t, P) |
| RS- 20 ℃ | 122.33± 18.661 | 133.67±9.887 (-1.415, 0.195) | 91.11±19.484 (2.693, 0.027) | 57.67±3.606 (9.358, 0.000) | 26.44±4.304 (13.115, 0.000) | 11.33±2.062 (16.960, 0.000) | 1.78±2.489 (18.180, 0.000) |
| RS- 80 ℃ | 122.33± 18.661 | 128.00±7.906 (-1.083, 0.310) | 125.33±5.958 (-0.477, 0.646) | 102.33±5.074 (2.603, 0.031) | 82.33±13.964 (3.789, 0.005) | 84.00±14.491 (3.546, 0.008) | 59.33±17.428 (5.387, 0.001) |
| RS- 196 ℃ | 122.33± 18.661 | 140.33±17.875 (-1.517, 0.168) | 139.33±13.537 (-1.612, 0.146) | 104.67±16.302 (1.631, 0.142) | 74.67±6.278 (3.838, 0.005) | 72.33±3.819 (5.349, 0.001) | 57.33±9.179 (7.240, 0.000) |
| DW- 20 ℃ | 151.00± 35.577 | 24.00±2.291 (11.084, 0.000) | 0.78±0.833 (12.570, 0.000) | 0.11±0.333 (12.669, 0.000) | 0±0 (12.733, 0.000) | 0±0 (12.733, 0.000) | 0±0 (12.733, 0.000) |
| DW- 80 ℃ | 151.00± 35.577 | 44.67±9.912 (8.889, 0.000) | 13.00±2.739 (12.411, 0.000) | 4.33±2.872 (11.470, 0.000) | 0±0 (12.733, 0.000) | 0±0 (12.733, 0.000) | 0±0 (12.733, 0.000) |
| DW- 196 ℃ | 151.00± 35.577 | 88.33±6.764 (4.825, 0.001) | 46.33±9.000 (8.753, 0.000) | 17.67±6.764 (10.099, 0.000) | 12.00±7.194 (10.045, 0.000) | 6.67±3.162 (11.338, 0.000) | 2.33±1.225 (12.345, 0.000) |
| Ref: Reference group, RS: Rabbit serum, DW: Drinking water. | |||||||
从保藏温度对结果影响方面来看,血清模拟样本在液氮条件下,冻融3次后与基准值F0差异不显著;在-80 ℃条件下,冻融2次后与基准值F0差异不显著;在-20 ℃条件下,只有冻融1次后与基准值F0差异不显著,其余都与基准值F0有显著性差异。
从不同样本基质,对结果影响方面来看,血清模拟样本中大肠埃希菌活性在-20 ℃、-80 ℃和液氮条件下冻融1~3次后部分结果与基准值差异不显著,但从冻融第4次开始,血清模拟样本中大肠埃希菌活性均与基准值F0存在显著性差异,菌落数量随着冻融次数增加而减少。饮用水模拟样本在-20 ℃、-80 ℃下,第4、5、6次冻融后菌落计数结果均为0。

|
| A: Rabbit serum; B: Drinking water. 图 4 不同保藏温度、冻融次数下大肠埃希菌在样本中的活性比较 Fig. 4 Comparison of the activity of Escherichia coli in samples at different holding temperatures and different freeze-thaw times |
采用浓度分别为0%、10%、50%、90%的兔血清样本分别在-20 ℃和-80 ℃的保藏温度下,经过1、3、5次冻融后,观察每次冻融后不同浓度兔血清样本中大肠埃希菌活性的变化(见图 5),从血清浓度对大肠埃希菌活性的影响来看,血清模拟样本中菌落数随着兔血清浓度的增加而增加,说明在冻融过程中血清对大肠埃希菌有保护作用,并且随着血清浓度的增加,保护作用增强。-20 ℃下的反复冻融与-80 ℃下的反复冻融相比,相同浓度的血清保护作用呈减弱趋势。

|
| A: -20 ℃; B: -80 ℃ 图 5 不同温度、冻融次数下大肠埃希菌在兔血清样本中的活性比较 Fig. 5 Comparison of the activity of Escherichia coli in rabbit serum samples with different temperatures and freeze-thaw times |
目前,将生物样本质量检测结果的影响因素以分析实验为界,分为分析前因素(pre-analytical factors)与分析因素(analytical factors)[12],其中分析前因素包括:样品供体个体差异、样品采集相关因素(抗凝剂种类、采集后暂存温度、采集用试管)、前处理因素(体液样品离心速度和时间、分装大小和体积、运输温度和时间)以及收集、处理、存储过程中的技术方案差异等。分析因素主要是指在分析过程中采取的阴性、阳性对照、标准操作程序(standard operating procedure,SOP) 等措施,以尽量减少分析过程中的质量误差,保证分析结果的准确性。样本库工作质量控制中的温度控制环节是贯穿于样本采集、转运、暂存、利用全周期流程的重要指标[13],不同温度下的冻融循环是生物样本保藏环节影响样本质量的重要因素之一[14]。感染性血清和水体样本是公共卫生研究领域常采集的标本种类[15],常被用于人群感染性疾病监测、暴发疫情的环境监测等[16],样本质量对判定疫情结果、确保科学研究的可靠性尤为重要。细菌活性是许多鉴定试验的基础,也是判断样本感染性强弱的金标准。
本研究模拟了公共卫生实验室常用感染性样本类型的实验工作场景,包括运输、暂存和反复冻融,并选取时间、温度和冻融次数这3个影响感染性样本质量的变量,评价其叠加效应对感染性样本活性的影响,从而探索可用于今后对生物样本库其他类型样本全流程质量评价的方法。依据研究数据结果,对血清和环境水体样本中的细菌类微生物学检验样本转运、暂存和冻融次数进行归纳,形成《细菌类微生物样本转运、暂存和冻融次数分级评价表》(见表 5)。如果样本保藏后续实验目的为定量,或者样本中微生物初始数量较低,建议优先选择“优”级评价标准。
| Sample type | Grade | Transit/temporary storage (temperature/time) | Freeze-thaw times (temperature/times) |
| RS | Excellent | Frozen CO2 (t≤24 h) | -196 ℃ (n≤3); -80 ℃ (n≤2); -20 ℃(n=1) |
| Good | Frozen CO2 (24 h<t≤48 h) 4 ℃ (12 h≤t≤48 h) | -80 ℃ (3<n≤5); -196 ℃(3<n≤5) -20 ℃(n=2) | |
| Unsuggested | 18 ℃(t≥2 h) | -20 ℃ (n≥3); -80 ℃ (n≥5) -196 ℃ (n≥5) | |
| DW | Excellent | 18 ℃/4 ℃ (t≤12 h) | -196 ℃ (n≤1) |
| Good | 18 ℃ (12 h≤t≤48 h) | -80 ℃ (n≤1); -196 ℃ (n=2) | |
| Unsuggested | Frozen CO2 | -20 ℃ | |
| RS: Rabbit serum, DW: Drinking water. | |||
病原菌监测是公共卫生监测工作中非常重要的部分,经过历次重大疫情的考验,疾病预防控制机构的病原学检验检测能力不断提升,与医院临床机构的合作日益紧密。规范感染性血液生物样本采集、转运、保藏是保证病原检测质量的重要环节。避免血液中微生物的活性在采集、转运、保藏流程中降低,是公共卫生生物样本库开展样本质量控制工作的关键点,直接影响了病原微生物的检出率,因此,疾病预防控制机构针对微生物学检验应有更严格的转运温度、时限和冻融循环最高次数的限制要求。根据《临床微生物检验基本技术标准》(WS/T 805-2022)[17]、《临床微生物实验室血培养操作规范》(WS/T 503-2017)[18]要求,临床血液标本采集后即注入需氧血培养瓶或厌氧血培养瓶,在2 h内送至实验室孵育或上机,如果不能及时送检,应将血培养瓶置于室温下保存,但未给出保存最长时限建议。同时,临床微生物检验血液标本规定,须向检测实验室提供采集标本的方法和容器、采集时间、采集后的储存及运送条件(包括温度和时限)等信息。
本研究中感染性血清模拟样本在18 ℃环境下暂存12 h后,大肠埃希菌菌落数与基准值相比增加约5倍;在4 ℃环境下暂存12 h后,大肠埃希菌菌落数与基准值相比略有下降,在干冰环境下暂存12 h后,大肠埃希菌菌落数与基准值相比差异不显著,建议感染性全血标本如果不能在2 h内及时送检,可分离血清后在24 h内使用干冰转运/暂存。如果无法在48 h内转运至生物样本库保藏,可选择于-196 ℃、-80 ℃临时实验室保藏,后续涉及样本分装、保藏、再利用的冻融总次数控制在2~3次。-20 ℃条件下仅可冻融一次。
《生活饮用水卫生标准》(GB5749-2022)[19]对生活饮用水的常规水质指标中总大肠菌群、大肠埃希菌和菌落总数限值均做出了要求,其配套规范性引文《生活饮用水标准检验方法第12部分:微生物指标》[20]规定了相应的检验方法,均以分离培养为基础,但是国标中没有说明水样在进入实验室检验前的转运、暂存和保藏的温度和时限。根据本研究结果,如要检测饮用水中的细菌指标,建议18 ℃条件下,12 h内运至实验室检测,最长不要暂存超过48 h。不建议使用干冰运输水样,因其会导致水中细菌活性急剧下降。饮用水长期保藏建议首选液氮保藏[21],后续涉及水样分装、保藏、再利用的冻融总次数控制在2次。
目前,针对生物样本库保藏利用过程中的冻融循环对细菌活性降低的影响机制暂无深入研究。有研究发现,冻融循环会导致样本中的核酸降解,浓度与纯度均下降[22],这可能是本研究模拟血清样本和饮用水样本多次冻融后细菌活性降低的原因之一。本研究亦发现,兔血清对细菌反复冻融后有保护作用,并且保护作用随着血清浓度的增加而增强,其保护原理是否与目前实验室常用的甘油类保护剂相似,须后续实验分析冻融循环前后细菌的核酸数量和完整性,结合细菌活性变化再探讨。
公共卫生样本库中生物样本入库前,样本的采集方、转运方、分装方涉及环节多[23],应全程记录每个环节影响样本质量的关键数据[24],例如:转运温度、时限和冻融循环总次数,可作为分析前信息记入生物样本库信息系统,尽管这不是生物样本操作信息,但可直接影响检验结果的准确性。根据样本种类和研究类型选择转运/暂存温度,严格控制分析前的冻融次数。
本研究存在如下不足之处,如:感染性血液样本细菌评价种类未考虑需氧菌、厌氧菌和苛养菌的活性差别,未考虑血浆血清差异和抗凝剂对细菌活性的影响,未评价地表水等菌落数较高的高背景水体样本[25]。这些不足之处在今后实验设计中应予以充分考虑。本研究采用兔血清样本、饮用水样本模拟感染性人类血液样本及环境水样在采集、运输、暂存、保藏环节中的菌落总数变化情况,并对不同保藏方法做出了评价,为保证样本质量管理要求的制定提供了科学的数据参考。
| [1] |
吴立梦, 祖平, 何蓉, 杨丹桐, 夏寒, 庄宇, 胡逸欢, 刘览, 邵岑怡, 操仪, 张伊人, 周瑶涵, 肖萍. 生物样本库建设管理现状与建议[J]. 中国卫生资源, 2022, 25(6): 790-798. [DOI]
|
| [2] |
吴立梦, 祖平, 何蓉, 杨丹桐, 夏寒, 庄宇, 胡逸欢, 刘览, 邵岑怡, 操仪, 张伊人, 周瑶涵, 肖萍. 区域生物样本库的建立及质量控制[J]. 中国标准化, 2022(12): 169-173. |
| [3] |
凌利芬, 陆学东, 汤一苇. 血流感染的实验室诊断进展研究[J]. 中华医院感染学杂志, 2018, 28(14): 2234-2240. |
| [4] |
许丽, 李伟, 孙学会, 苏燕, 陈兴栋, 徐萍. 大型队列建设模式与运行机制及其启示[J]. 中国卫生资源, 2021, 24(6): 739-743. [DOI]
|
| [5] |
Vogtmann E, Goedert JJ. Epidemiologic studies of the human microbiome and cancer[J]. Br J Cancer, 2016, 114(3): 237-242.
[DOI]
|
| [6] |
Järbrink-Sehgal E, Andreasson A. The gut microbiota and mental health in adults[J]. Curr Opin Neurobiol, 2020, 62: 102-114.
[DOI]
|
| [7] |
Franzosa EA, Morgan XC, Segata N, Waldron L, Reyes J, Earl AM, Giannoukos G, Boylan MR, Ciulla D, Gevers D, Izard J, Garrett WS, Chan AT, Huttenhower C. Relating the metatranscriptome and metagenome of the human gut[J]. Proc Natl Acad Sci USA, 2014, 111(22): E2329-E2338.
|
| [8] |
Poulsen CS, Kaas RS, Aarestrup FM, Pamp SJ. Standard sample storage conditions have an impact on inferred microbiome composition and antimicrobial resistance patterns[J]. Microbiol Spectr, 2021, 9(2): e0138721.
[DOI]
|
| [9] |
Biazzo M, Deidda G. Fecal microbiota transplantation as new therapeutic avenue for human diseases[J]. J Clin Med, 2022, 11(14): 4119.
[DOI]
|
| [10] |
陈丽羽, 耿焱. 粪菌移植技术中肠道噬菌体对疾病影响的研究进展[J]. 微生物与感染, 2023, 18(5): 297-306. [DOI]
|
| [11] |
范泽涵, 章月蟾, 索晨, 徐珂琳, 薛江莉, 李淑元, 袁子宇, 王久存, 金力, 陈兴栋. 冻存温度、冻融次数和冻存时间对血清生化指标稳定性的影响[J]. 转化医学杂志, 2018, 7(4): 212-217. |
| [12] |
王微, 王蕾. 分析前因素对临床生化检测结果的影响[J]. 检验医学, 2021, 36(4): 357-361. [DOI]
|
| [13] |
熊伟, 黄玉钗. 基于冷链监控系统规划生物样本库的建设与管理[J]. 中国医药生物技术, 2020, 15(5): 494-497. |
| [14] |
Tatangelo V, Franzetti A, Gandolfi I, Bestetti G, Ambrosini R. Effect of preservation method on the assessment of bacterial community structure in soil and water samples[J]. FEMS Microbiol Lett, 2014, 356(1): 32-38.
|
| [15] |
周进宏, 王晓昌, 徐丽梅. 小型景观水体中病原微生物的分布特性[J]. 环境工程学报, 2015, 9(12): 5689-5696. |
| [16] |
Wang Y, Li X, Chi Y, Song W, Yan Q, Huang J. Changes of the freshwater microbial community structure and assembly processes during different sample storage conditions[J]. Microorganisms, 2022, 10(6): 1176.
|
| [17] |
中华人民共和国国家卫生健康委员会. 临床微生物检验基本技术标准: WS/T 805-2022 [S/OL]. [2023-11-17].
http://www.nhc.gov.cn/cms-search/downFiles/899d38905e444 c6ab43c06a1e4826c71.pdf.
|
| [18] |
中华人民共和国国家卫生和计划生育委员会. 临床微生物实验室血培养操作规范: WS/T 503-2017 [S/OL]. [2023-11-17]. https://www.wiki8.cn/WS.2FT+503. E2.80.942017+linchuangweishengwushiyanshixuepeiyang caozuoguifan_161837/.
|
| [19] |
中华人民共和国国家市场监督管理总局, 中华人民共和国国家标准化管理委员会. 生活饮用水卫生标准: GB 5749-2022 [S]. 北京: 中国标准出版社, 2022.
|
| [20] |
中华人民共和国国家市场监督管理总局, 中华人民共和国国家标准化管理委员会. 生活饮用水标准检验方法第12部分: 微生物指标: GB/T 5750.12-2023 [S]. 北京: 中国标准出版社, 2023.
|
| [21] |
尹茹, 唐蓉, 郑春霞. 人类生物样本库及样本管理规范简介[J]. 肾脏病与透析肾移植杂志, 2023, 32(4): 348-352. |
| [22] |
王欢, 秦玲, 莎胡垚, 张恬, 张友良, 齐玲. 基于《生物样本库质量和能力认可准则》的质量管理评价体系构建[J]. 中国卫生资源, 2022, 25(4): 515-519. |
| [23] |
中华人民共和国国家市场监督管理总局, 中华人民共和国国家标准化管理委员会. 生物样本库质量和能力通用要求: GB/T 37864-2019 [S]. 北京: 中国标准出版社, 2019.
|
| [24] |
中华人民共和国国家市场监督管理总局, 中华人民共和国国家标准化管理委员会. 人感染病原微生物与样本保藏通用要求: GB/T 43429-2023 [S]. 北京: 中国标准出版社, 2023.
|
| [25] |
倪雅楠, 胡颖, 王易雪, 宋丽洁, 陈萌, 张连海. 生物样本库冷冻组织样本质量评估[J]. 山东医药, 2019, 59(27): 5-8. |
 2024, Vol. 19
2024, Vol. 19


